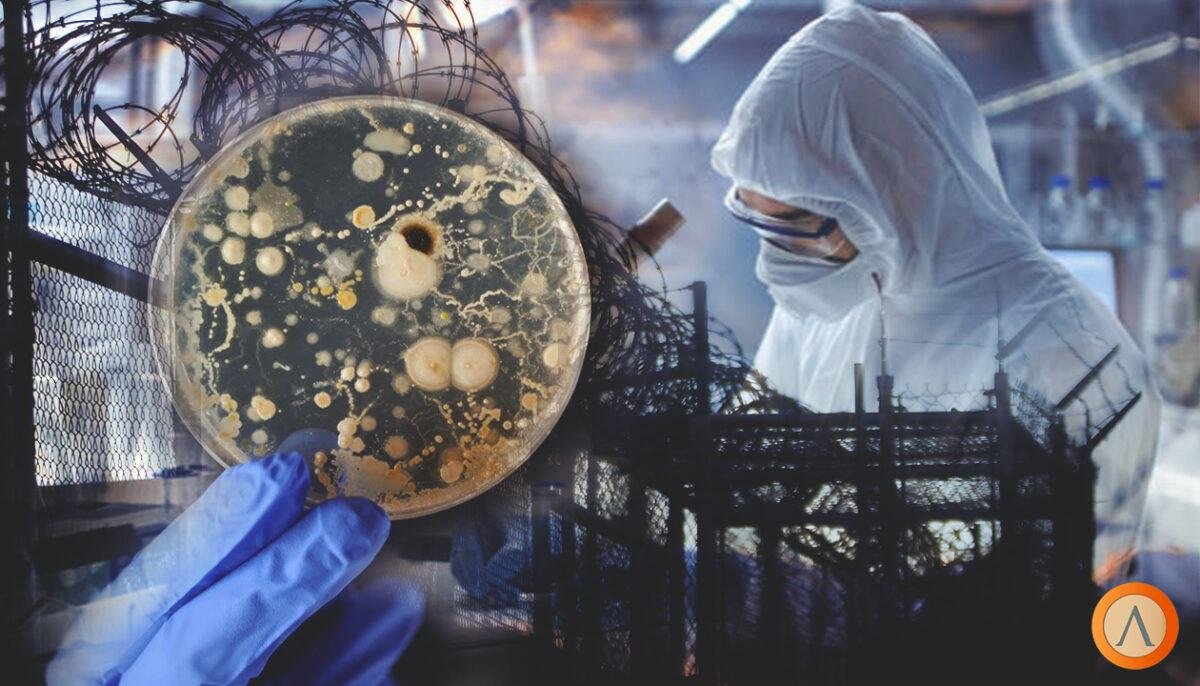

Уголовную ответственность за сбыт и хищение опасных патогенов введут в Казахстане
Мажилис в первом чтении одобрил законопроект.
В Казахстане намерены ввести уголовную ответственность за незаконное обращение, сбыт и хищение опасных патогенов, а также за нарушение требований обращения с ними, передает Liter.kz
На пленарном заседании Мажилис одобрил в первом чтении проект закона «О биологической безопасности Республики Казахстан» и сопутствующие поправки.
«Генеральная концепция законопроекта заключается в раннем выявлении, предотвращении и профилактике биологических угроз», - сказал 8 декабря министр здравоохранения Алексей Цой.
В законопроекте определяются основные источники биологических угроз, среди которых природные очаги особо опасных инфекций, завоз опасных инфекций, несанкционированный доступ к патогенным биоагентам, нерегулируемое и свободное их обращение, воздействие на источники повышенной опасности в результате чрезвычайных ситуаций и актов терроризма, а также недостаток квалифицированных кадров в области биобезопасности.
Минздрав намерен сформировать «эффективную систему противодействия таким угрозам», на что в проекте бюджета на 2022-2024 годы предусмотрено порядка 25 миллиардов тенге.
Сопутствующий законопроект в правительственной версии предусматривает внесение изменений в 13 законодательных актов, включая три кодекса и 10 законов.
«Законопроект включает введение точечного госконтроля на основе данных учета, мониторинга и оценки биорисков с исключением предварительного уведомления о предстоящей проверке организаций, осуществляющих обращение с наиболее опасными биоагентами, а также введение уголовной ответственности за незаконное обращение, сбыт и хищение опасных патогенов, а также за нарушение требований обращения с ними, повлекшие тяжкие последствия», - перечислил глава Минздрава.
Документом закрепляется лицензирование услуг по дезинфекции, дезинсекции и дератизации в области здравоохранения, конкретизируется система выдачи разрешений на все объекты, работающие с патогенами.
Законопроекты предусматривают шестимесячный переходный период для введения в действие, а также дополнительно шесть месяцев для оформления лицензий на оказание услуг по дезинфекции, дезинсекции и дератизации в области здравоохранения.
О создании новой системы биологической безопасности стало известно в сентябре. Подробнее о нем читайте здесь.


